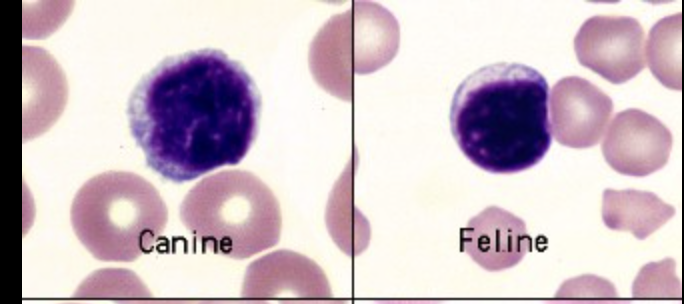
knowt flashcard image

clin path lab
1/24
There's no tags or description
Looks like no tags are added yet.
Name | Mastery | Learn | Test | Matching | Spaced | Call with Kai |
|---|
No analytics yet
Send a link to your students to track their progress
25 Terms
What does OSHA
Occupational Safety and Health Administration
What should the new container include for secondary container label?
Chemical name
Hazard warnings
Flammable
Toxic
Corrosive
Biohazard
What is a PCV what do PCV results mean?
it measures the percentage of blood made by RBC
low= anemia
high= dehydration, polycythemia
Normal PCV %
Canine: 37-55
Feline: 30-45
Performing a PCV
use a capillary tube to take in blood from purple tube
plug into clay to seal the tube
tube is placed in a centrifuge, if many spread it evenly
small animals pcv run in 3 minutes
read pcv using a reader card aling red blood at bottom and plasma at 100% and read where plasma and blood meet
do not include buffy coat in pcv
total protein using refractometer
using the centrifuged tube, break where plasa ends and gently tap into the refractometer window
read using the far right scale (whole numbers 1,2,3,4)
unit g/dL
parts of a PCV include
plasma
buffy coat
RBC

definitions of erythrocyte indices and how to interpret the results
MCV: mean corpuscular volume, RBC size
MCH: mean corpuscular hemoglobin, hemoglobin amount
MCHC: mean corpuscular hemoglobin concentration, concentration of hemoglobin -
larger cells= regenerative anemia
smaller cells= non regenerative anemia
Low hemoglobin= chronic anemia
evaluating cellular morphology
evaluation of physical features of cells
evaluating WBC differential
measures percentage of each WBC
all add up to 100%
Neutrophil cell

Lymphocyte
monocyte

Eosinophil

Basophil

WBC estimate
multiple by 2,000
40x objective
Platelet estimate
5 fields x 10,000
100x objective
Plasma vs Serum
Plasma→ has clotting factors and comes from anticoagulated tube
Serum→ no clotting factor and from clotted blood
Know the additives in different blood tubes, and the purpose of each blood tube
Purple tube→ EDTA for complete blood cell CBC
Green tube→ heparin for chemistry
Red→ no additive for serum
Blue→ citrate for coagulation tests
what do you use to calculate urine specific gravity
a refractometer look into U.G units
The 3 parts of a urinalysis
physical examination→ appearance of urine
chemical analysis → dipstick test, pH, glucose, protein etc.
sediment → microscopic examination after centifugation, cells, bacteria, crystals
From the three stations of the Diff Quick what are they and what helps?
Fixative: preserve cells (7)
Eosin stain: stain cytoplasm (5)
basophilic stain: stain nuclei (7)
What are the parts of a blood smear?
Body
Monolayer
Feather edge

Parts of test for chemistry
by centesis (abdomino, thoraco, arthro)
Lab samples needed for chemistry
For total protein measurement = non-anticoagulant tube (red tube)
For TNCC = EDTA tube